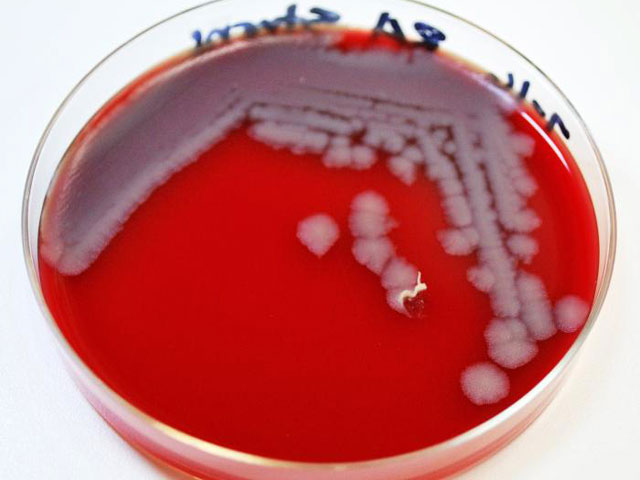

В Польше зафиксировали случай заражения домашнего скота сибирской язвой
Случай заражения смертельно опасным заболеванием - сибирской язвой - был зафиксирован на востоке Польши неподалеку от границы с Украиной после устрашающих сообщений о появлении инфекции в Венгрии.
Как сообщает Reuters, ветеринары выявили заражение у павшей лошади. Шесть животных, которые находились с ней в одном стаде, помещены в карантин, сообщила агентству Янина Войтас, представитель ветеринарной службы в городе Томашув-Любельский. Она добавила, что у лошадей не наблюдается признаков заражения, у всех животных нормальная температура. Однако власти на всякий случай приняли решение ограничить передвижение животных.
Агентство отмечает, что ранее сибирская язва была зафиксирована в Польше в 2001 году.
Между тем власти Венгрии заявили о нескольких случаях обнаружения спор сибирской язвы в произведенной в стране говядине. Возбудитель заболевания был найден в образцах говядины, произведенной в частном домохозяйстве в восточной области Хевеш на востоке страны, пишет РИА "Новости". Также Национальная служба здравоохранения Венгрии сообщила, что в Хевеше госпитализированы шесть человек с подозрением на сибирскую язву. Отмечается, что люди могли заразиться мясом, полученным в результате незаконного забоя скота.
На прошлой неделе сообщалось о вспышке сибирской язвы в другой части Венгрии. Национальная служба здравоохранения сообщает, что эти случаи не связаны между собой, и не исключает, что животные могли заболеть, пообедав зараженным кормом, пишет The Budapest Business Journal.
Часть инфицированного мяса была отправлена в компанию, поставляющую продукты предприятиям общественного питания. По решению властей деятельность компании временно приостановлена, начато расследование. В регионе, где выявлена вспышка инфекции, проведена массовая вакцинация животных.
Массовые заражения сибирской язвой происходят после наводнений. Источниками заражения становятся скотомогильники, поскольку в земле споры могут оставаться жизнеспособными в течение 100 лет. Отметим, в середине мая в Польше наблюдались подтопления.
Сибирская язва может быть смертельно опасной для всех видов сельскохозяйственных животных и человека. Ей можно заразиться от инфицированных животных или в результате контакта с зараженными продуктами животного происхождения. Заболевание не передается от человека к человеку, и его можно лечить с помощью антибиотиков, сообщается на сайте ВОЗ.
Существует три типа сибирской язвы: кожная, желудочно-кишечная и легочная. Заболевание характеризуется интоксикацией, воспалениями кожи, лимфатических узлов и внутренних органов.